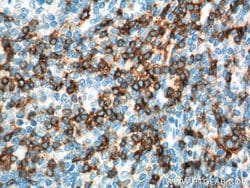

Promotional price valid on web orders only. Your contract pricing may differ. Interested in signing up for a dedicated account number?
Learn More
Learn More
CD7 Mouse anti-Human, Mouse, Clone: 1G10D8, Proteintech


Mouse Monoclonal Antibody
$518.60
Specifications
| Antigen | CD7 |
|---|---|
| Clone | 1G10D8 |
| Concentration | 1.1 mg/mL |
| Applications | Immunohistochemistry (Paraffin) |
| Classification | Monoclonal |
| Catalog Number | Mfr. No. | Quantity | Price | Quantity & Availability | |||||
|---|---|---|---|---|---|---|---|---|---|
| Catalog Number | Mfr. No. | Quantity | Price | Quantity & Availability | |||||
50-173-6312
 
|
Proteintech Group Inc
602091IG150UL |
150 μL |
Each of 1 for $518.60
|
|
|||||
Description
CD7 (gp40, Leu9) is a 40 kDa member of the immunoglobulin gene superfamily. CD7 contains N-terminal amino acids 1-107 are highly homologous to Ig kappa-L chains whereas the carboxy-terminal region of the extracellular domain is proline-rich and has been postulated to form a stalk from which the Ig domain projects. CD7 is expressed on the majority of immature and mature T-lymphocytes, and T cell leukemia. Further, CD7 is also found on natural killer cells, a small subpopulation of normal B cells and on maligt B cells. Cross-linking surface CD7 positively modulates T cell and NK cell activity as measured by calcium fluxes, expression of adhesion molecules, cytokine secretion and proliferation. CD7 associates directly with phosphoinositol 3′-kinase. CD7 ligation induces production of D-3 phosphoinositides and tyrosine phosphorylation. Expression of CD7 is an important marker used in leukemia diagnostics.Specifications
| CD7 | |
| 1.1 mg/mL | |
| Monoclonal | |
| Liquid | |
| RUO | |
| PBS with 50% glycerol and 0.02% sodium azide; pH 7.3 | |
| CD7, CD7 molecule, GP40, LEU 9, T cell antigen CD7, T cell leukemia antigen, T cell surface antigen Leu 9, Tp40, TP41 | |
| CD7 | |
| IgG1 | |
| Protein G | |
| Antibody |
| 1G10D8 | |
| Immunohistochemistry (Paraffin) | |
| Unconjugated | |
| Mouse | |
| Human, Mouse | |
| P09564, P50283 | |
| 12516, 924 | |
| CD7 Fusion Protein Ag1805 | |
| Primary | |
| -20°C | |
| CD7 |
Spot an opportunity for improvement?Share a Content Correction
Product Content Correction
The Fisher Scientific Encompass Program offers items which are not part of our distribution portfolio. These products typically do not have pictures or detailed descriptions. However, we are committed to improving your shopping experience. Please use the form below to provide feedback related to the content on this product.
Product Title